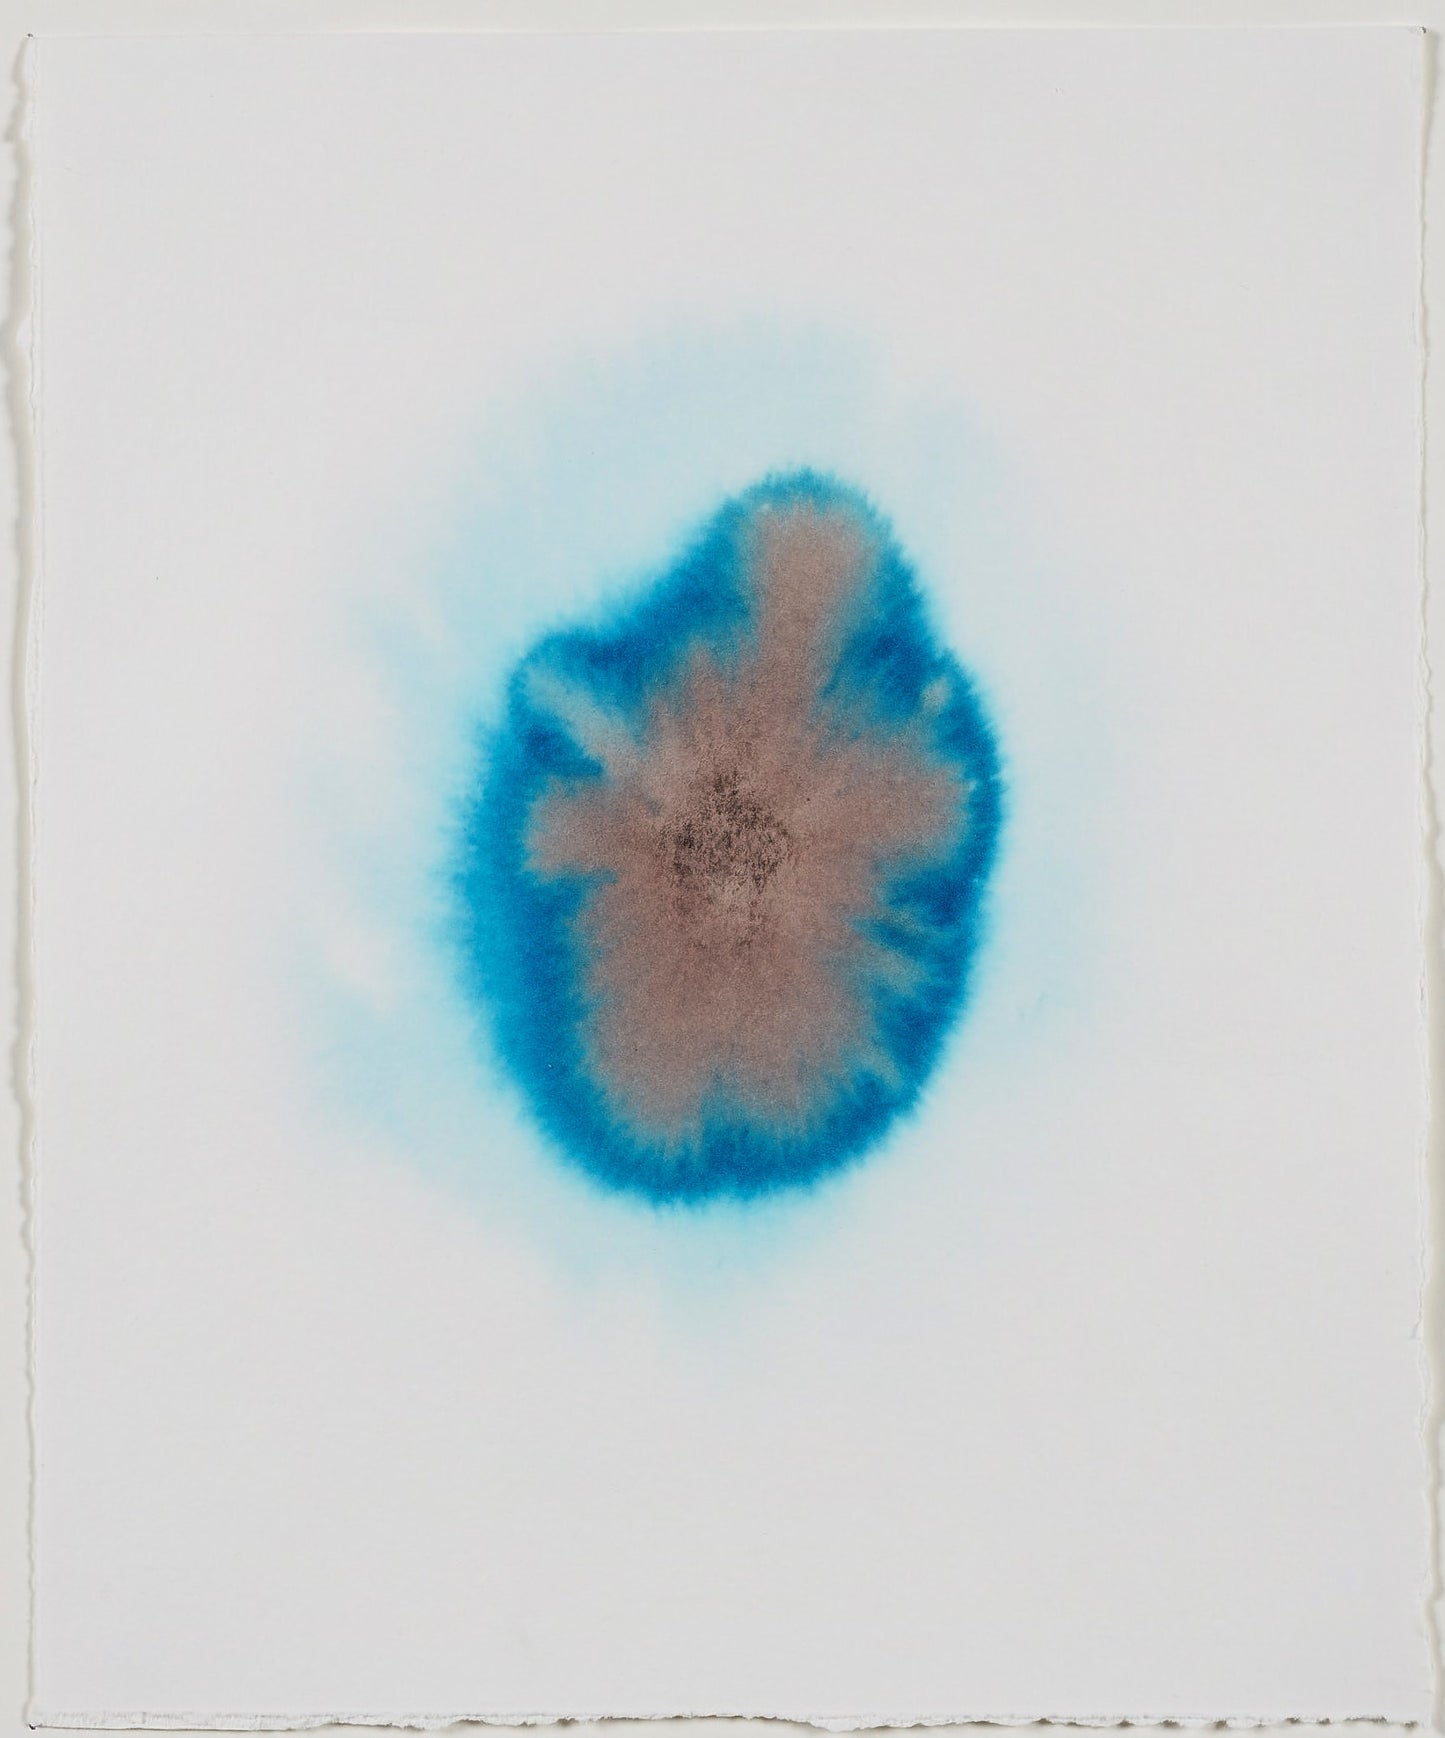
Opløsning

Kirstine Vaaben
Opløsning
Normalpris
2.800 kr
Normalpris
Udsalgspris
2.800 kr
Stykpris
pr.
i hvid ramme
Akvarel, tusch og blæk på papir
Lavet 2021
24 32 cm
Mere af Kirstine Vaaben
-
Kirstine Vaaben
Uden titel
24 17 cmUdsalg SolgtNormalpris 1.500 krNormalprisStykpris pr. -
Kirstine Vaaben
Uden titel
100 70 cmUdsalg SolgtNormalpris 15.000 krNormalprisStykpris pr. -
Kirstine Vaaben
Collage i ramme
44 60 cmUdsalg SolgtNormalpris 6.000 krNormalprisStykpris pr. -
Kirstine Vaaben
Collage i ramme
44 59.5 cmUdsalg SolgtNormalpris 6.000 krNormalprisStykpris pr. -
Kirstine Vaaben
Collage i ramme
43 57 cmUdsalg SolgtNormalpris 6.000 krNormalprisStykpris pr. -
Kirstine Vaaben
Uden titel
45 61 7.5 cmUdsalg SolgtNormalpris 6.500 krNormalprisStykpris pr. -
Kirstine Vaaben
Collage i ramme
35.5 48 cmUdsalg SolgtNormalpris 6.500 krNormalprisStykpris pr. -
Kirstine Vaaben
Uden titel
Udsalg SolgtNormalpris 1.500 krNormalprisStykpris pr. -
Kirstine Vaaben
Uden titel
115 153 cmUdsalg SolgtNormalpris 25.000 krNormalprisStykpris pr.












